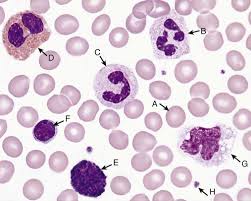

Franciscan Missionaries of Our Lady University - Moodle
Search results: 202

Human Anatomy & Physiology I
Category: MUS Testing
Clinical Education I. 08/15/2022-12/03/2022 Face to Face Tuesday, Thursday 08:30AM - 10:00AM, Health Profession, Room 210
- Teacher: April Graham

Clinical Science II. 08/15/2022-12/03/2022 Face to Face Tuesday, Thursday 10:15AM - 12:00PM, Health Profession, Room 210 (more)...
- Teacher: April Graham
Ethics, Personnel Supervision. 08/15/2022-11/30/2022 Face to Face Monday, Wednesday 04:30PM - 05:45PM, Liberal Arts, Room 108
- Teacher: Tanisha Woods
Surgical Skills
- Teacher: Josselin Carter
- Teacher: Rachel Chappell
- Teacher: Michael Falba
- Teacher: Melissa Lemoine
- Teacher: Tara Milligan
- Teacher: Lucas Spence
Hospital Medicine
- Teacher: Alicia Brand
- Teacher: Josselin Carter
- Teacher: Michael Falba
- Teacher: Melissa Lemoine
- Teacher: Tara Milligan

Intermediate Spanish I
- Teacher: Ghedy Matus
Bioethics
- Teacher: Josselin Carter
- Teacher: Callie Dorn
- Teacher: Valerie Schluter


Adv Health Assess & Promotion
- Teacher: Mandy Broussard
- Teacher: Ross Castille
- Teacher: Beth Crochet
- Teacher: Katrina O'Con
- Teacher: Amber Poirrier
- Teacher: Lindsay Williams
Category: 2025 Fall
Adv Health Assess & Promotion
- Teacher: Shelita Bates
- Teacher: Leon Gallow
- Teacher: May Milazzo
Category: 2025 Fall
Adv Hlth Assess & Promotion
- Teacher: Shelita Bates
- Teacher: Leon Gallow
- Teacher: May Milazzo
Category: 2025 Fall
Adv Orthopedic Phys Therapy I
- Teacher: Jaime Caillet
- Teacher: Ronald Helwig
- Teacher: Mari Kantrow
Category: 2025 Fall

Clinical Medicine Skills Lab
- Teacher: Josselin Carter
- Teacher: Rachel Chappell
- Teacher: Matthew Chappellie
- Teacher: Michael Falba
- Teacher: Tara Milligan
- Teacher: Jolie Relle
Category: 2025 Fall
Clinical Medicine Skills Lab
- Teacher: Josselin Carter
- Teacher: Rachel Chappell
- Teacher: Matthew Chappellie
- Teacher: Michael Falba
- Teacher: Tara Milligan
- Teacher: Jolie Relle
Category: 2025 Fall
Clinical Medicine Skills Lab
- Teacher: Josselin Carter
- Teacher: Rachel Chappell
- Teacher: Matthew Chappellie
- Teacher: Michael Falba
- Teacher: Tara Milligan
- Teacher: Jolie Relle
Category: 2025 Fall
Clinical Medicine Skills Lab
- Teacher: Josselin Carter
- Teacher: Rachel Chappell
- Teacher: Matthew Chappellie
- Teacher: Michael Falba
- Teacher: Tara Milligan
- Teacher: Jolie Relle
Category: 2025 Fall


Found of Clin Med & Surg III
- Teacher: Josselin Carter
- Teacher: Rachel Chappell
- Teacher: Matthew Chappellie
- Teacher: Tara Milligan
- Teacher: Jolie Relle
- Teacher: Jessica Templet
Category: 2025 Fall

General Organic Chem I
- Teacher: Dixie Gautreaux
- Teacher: Natalie Lenard
- Teacher: Daphne Moore
Category: 2025 Fall


Health Systems and Trends
Health care administrators must possess a comprehensive understanding of the current healthcare delivery system. Effective leadership requires staying informed about the external dynamics that shape the provision of services to communities, as well as the internal factors that influence daily organizational operations. A leader’s awareness of these forces supports the development of practical solutions, innovative programs, and advocacy for policies that benefit
patients, staff, and other key stakeholders.
Through a case study–based learning approach, students will critically examine healthcare structures, levels, and formats of care, governance, industry segments, workforce dynamics, utilization and access issues, care models, facilities, informatics, and technological advancements. Students will build upon their existing knowledge of regulatory policies and value-based reimbursement trends, applying these concepts to case analyses. In doing so, they will evaluate
healthcare systems, propose strategies for growth and continuous improvement, and anticipate future programmatic and policy needs.
Health care administrators must possess a comprehensive understanding of the current healthcare delivery system. Effective leadership requires staying informed about the external dynamics that shape the provision of services to communities, as well as the internal factors that influence daily organizational operations. A leader’s awareness of these forces supports the development of practical solutions, innovative programs, and advocacy for policies that benefit
patients, staff, and other key stakeholders.
Through a case study–based learning approach, students will critically examine healthcare structures, levels, and formats of care, governance, industry segments, workforce dynamics, utilization and access issues, care models, facilities, informatics, and technological advancements. Students will build upon their existing knowledge of regulatory policies and value-based reimbursement trends, applying these concepts to case analyses. In doing so, they will evaluate
healthcare systems, propose strategies for growth and continuous improvement, and anticipate future programmatic and policy needs.
- Teacher: Angelette Evans
- Teacher: Elaine Purdy
Category: 2025 Fall












- Teacher: Belinda Munson
- Teacher: Francine Thomas
Category: 2025 Fall


Performance Improvement in Healthcare:
This undergraduate course introduces the fundamental concepts of performance improvement in healthcare. Students will explore the history, language, and tools of quality improvement, with emphasis on understanding basic methodologies, team collaboration, and the importance of patient-centered care. The course is designed to build foundational knowledge that prepares students for professional practice or advanced study in healthcare administration.
This undergraduate course introduces the fundamental concepts of performance improvement in healthcare. Students will explore the history, language, and tools of quality improvement, with emphasis on understanding basic methodologies, team collaboration, and the importance of patient-centered care. The course is designed to build foundational knowledge that prepares students for professional practice or advanced study in healthcare administration.
- Teacher: Angelette Evans
Category: 2025 Fall
Pharmacotherapeutics II
- Teacher: Josselin Carter
- Teacher: Rachel Chappell
- Teacher: Matthew Chappellie
- Teacher: Jeffery Evans
- Teacher: Tara Milligan
- Teacher: Jolie Relle
Category: 2025 Fall








- Teacher: Christopher Ragusa
- Teacher: Hannah Ragusa
Category: 2025 Fall

Translational Research
- Teacher: Meridith Bergeron
- Teacher: Mandy Broussard
- Teacher: Ross Castille
- Teacher: Beth Crochet
- Teacher: Janice Hall
- Teacher: Lucas Huntington
- Teacher: Hylda Nugent
- Teacher: Katrina O'Con
- Teacher: William Schreiter
- Teacher: Joshua Todd
- Teacher: Lindsay Williams
Category: 2025 Fall


Human Anatomy & Physiology I
- Teacher: Dawn Simms
- Teacher: Michael Ludwig
- Teacher: Timothy Nelson
- Teacher: Jennifer Watson
Category: 2025 Fall
College Algebra CoReq Needed
- Teacher: Paul Britt
CoRequisite College Algebra
- Teacher: Paul Britt
Found Clin Med & Surg V
- Teacher: Josselin Carter
- Teacher: Rachel Chappell
- Teacher: Amanda Olinde
Found of Clin Med & Surg IV
- Teacher: Josselin Carter
- Teacher: Tara Milligan
Integrated Capstone
- Teacher: Elaine Purdy
PA Hist & Profess Issues
- Teacher: Josselin Carter
- Teacher: Michael Falba
- Teacher: Tara Milligan
Patient Assessment Lab - Wednesday
- Teacher: Josselin Carter
- Teacher: Tara Milligan
- Teacher: Haley Smith
Plane Trigonometry
- Teacher: Paul Britt
Professional Practice III
- Teacher: Mari Kantrow
Psychosocial Dynamics in Heal
- Teacher: Josselin Carter
- Teacher: Rachel Chappell
Radiographic Anat & Proced II
- Teacher: Rebecca Simoneaux
Radiographic Pathology
- Teacher: Rebecca Simoneaux
Radiology
- Teacher: Josselin Carter
- Teacher: Tara Milligan
- Teacher: Case Rappelet
- Teacher: Emily Richard
Theology of the Church
- Teacher: Terence Ellis

Trinitarian Theology
- Teacher: Tyler Pellegrin
- Teacher: Esther Penns
Category: Miscellaneous


- Teacher: Catherine Alexander
- Teacher: Jeremy Cinman
- Teacher: Sarah Goncalves
- Teacher: Tabitha Jones-Thomas
- Teacher: Natalie Lenard
- Teacher: Amit Mitra
- Teacher: Daphne Moore
- Teacher: Amanda Olinde
- Teacher: Phillip Page
- Teacher: Amber Poirrier
- Teacher: Christopher Ragusa
- Teacher: Hannah Ragusa
- Teacher: Rhoda Reddix
- Teacher: William Schreiter
- Teacher: Angus Woodward
Category: Miscellaneous
- Teacher: Alicia Bates
- Teacher: Lindsay Bratton-Mullins
- Teacher: Kristin Harris
- Teacher: Elaine Purdy
- Teacher: Tasha Womack
Category: 2025 Fall
- Teacher: Laurinda Calongne
Category: Course templates
- Teacher: Instructor Demo
- Teacher: Mitchell Stolier
- Teacher: Chaz Wu
Category: Miscellaneous

Adv Medical Nutrition Therapy
- Teacher: MoodleUS Admin
- Teacher: Kathryn Fakier
- Teacher: Kristina Porthouse
Category: MUS Testing

Blog at WordPress.com https://thelifeofastudentnurse.home.blog/
- Teacher: Latonya Dorsey
- Teacher: Amy Hall
- Teacher: Carla Harmon
- Teacher: Jasmine McClendon
Category: Miscellaneous
- Teacher: Latonya Dorsey
- Teacher: Amy Hall
- Teacher: Carla Harmon
- Teacher: Jasmine McClendon
Category: Miscellaneous
- Teacher: Josselin Carter
- Teacher: Michael Ludwig
Category: 2025 Fall
- Teacher: Josselin Carter
Category: classes
The Empowering Futures Project: Vocational Discernment Cohort for Student Development Program is a dynamic 6-week course aimed at helping students explore and clarify their vocation, purpose, and core values. Through guided reflection and interactive activities, you will learn how to support students in discovering their strengths, passions, and values while integrating faith practices to deepen their understanding of their unique callings. This course will equip you with the tools and insights to foster meaningful change within the student population and inspire them as they navigate their academic and professional paths.
- Teacher: Keyo Johnson
- Teacher: Esther Penns
Category: Miscellaneous
- Teacher: Laurinda Calongne
- Teacher: Valerie Schluter
Category: Miscellaneous

- Teacher: Sue Davis
- Teacher: Rhoda Reddix
Category: Miscellaneous



